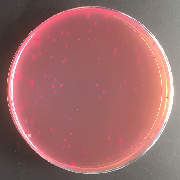
大腸菌群を培養した培地の写真

食品の細菌検査
食品が清潔な場所で安全に作られているかといった衛生管理の指標となる一般細菌数や大腸菌群、食中毒の原因となる細菌等がいないかを検査します。検査の方法は調べたい細菌によって異なります。ここでは、その検査方法の一つを紹介します。
検査の流れ
1 食品を細かく切り、量り採る
食品中の細菌を正確に検出するため、操作はすべて無菌的に行います。

2 希釈水と混ぜる
食品から希釈水に細菌を取り出します。
3 希釈水をシャーレ等に入れる
細菌を増やすためのシャーレ(平皿)や試験管に入れます。

4 培地を加えて混ぜる
目的とする細菌ごとに様々な培地を加えます。

5 培養して、細菌を増やす
一定の温度で保管できる装置に入れて、培養します。
例えば、一般細菌数の検査では、35度(誤差はプラスマイナス1度の範囲)で24から48時間培養します。
6 結果を判定します
細菌の集落(コロニー)数の計測や、形状・色の確認等をします。追加試験を行うこともあります。結果から、食品が適切に取り扱われているかどうかが分かります。
このページに関するお問い合わせ
健康福祉局 生活衛生部 食品衛生検査所 監視検査担当
電話番号:052-671-3371 ファクス番号:052-671-3383
Eメール:a6713371@kenkofukushi.city.nagoya.lg.jp
健康福祉局 生活衛生部 食品衛生検査所 監視検査担当へのお問い合わせ
